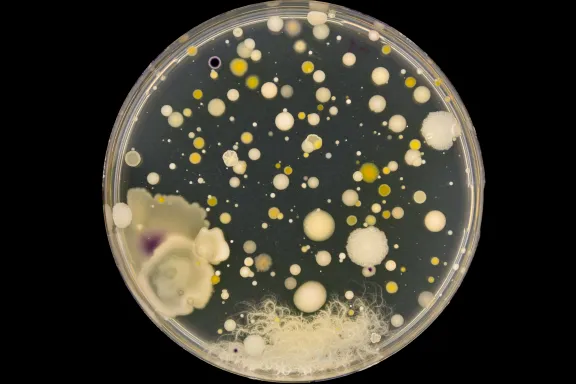

Athanasios Typas Créer des bactéries modèles pour découvrir le trésor caché du microbiote intestinal humain
Athanasios Typas, Chef de l’équipe « Systems microbiology » dans l’unité de Biologie des génomes et l’unité structurale et computationnelle à l’EMBL, Heidelberg, Allemagne. Co-titulaire de la chaire « Microbial Ecosystems and Infection Biology »
- 2022 • Prix Liliane Bettencourt pour les sciences du vivant

Composé de plus de cinq cents espèces bactériennes et contenant cent fois plus de gènes que dans notre propre génome, le microbiote qui colonise l’intestin humain offre des opportunités inestimables pour la médecine de demain. Les travaux orchestrés par Athanasios Typas seront la clé pour accéder à ce trésor de propriétés inconnues.
La mine d’or du microbiote humain
Le corps humain contient autant de cellules bactériennes que de cellules humaines. Ce grand ensemble de microbes constitue le microbiote humain, dont la partie la plus importante réside dans notre intestin. Il a été récemment établi que le microbiote intestinal a des effets multiples et variés sur la santé et le bien-être humain, bien au-delà de l’aide à la digestion des aliments et au développement du système immunitaire. Son impact est autant local, par la protection contre des maladies gastro-intestinales, que global, avec des effets sur notre cerveau et notre comportement. Ainsi, le microbiote intestinal humain reçoit de plus en plus d’attention du fait de son grand potentiel thérapeutique. Mais sans connaitre l’identité et les propriétés des microorganismes qui le constituent, il est impossible d’aller plus loin dans cette direction.
Athanasios Typas et le microbiote humain
Depuis la création de son équipe de recherche en 2011 à l’EMBL, Athanasios Typas développe des techniques à haut débit pour étudier les bactéries et les interactions hôte-pathogène, découvrir les modes d’actions et interactions de produits pharmaceutiques, et lutter contre l’antibiorésistance. Ainsi, il a mis en évidence que les médicaments non antibiotiques ont un impact direct et surprenant sur le microbiote intestinal, et que les microbes qui le composent peuvent accumuler ces médicaments et modifier ainsi leur disponibilité pour le corps humain. De plus, il a découvert des molécules antidotes pour contrer les dommages collatéraux des antibiotiques sur les microbes intestinaux tout en préservant leur activité contre les bactéries pathogènes. Toutes les capacités et fonctions des microbes intestinaux sont codées dans leurs génomes. Pourtant, ces génomes restent largement méconnus, car ils ne ressemblent en rien aux microbes étudiés depuis des décennies dans les laboratoires, comme la bactérie E. coli. Et si les médicaments de demain se trouvaient dans cette vaste information inconnue ?
Ciao E. coli, bonjour Bacteroidota
Pour aller plus loin dans la relation cause à effet du microbiote sur la santé, il est nécessaire de créer des organismes modèles de microbiote intestinal humain pertinents et de pouvoir les étudier en laboratoire. Pour ce faire, Athanasios Typas rassemblera les efforts et les expertises de plusieurs groupes de recherche à l’EMBL pour révolutionner la façon de créer des organismes modèles, qui auparavant prenait des dizaines d’années et le travail de centaines de laboratoires. En combinant des approches expérimentales et computationnelles de pointe, les cibles initiales de cette étude seront deux des espèces les plus abondantes et les plus courantes du microbiote intestinal humain, appartenant au phylum des Bacteroidota : Phocaeicola vulgatus et Bacteroides uniformis. La dotation du Prix Liliane Bettencourt pour les sciences du vivant permettra au projet de recherche de Athanasios Typas de se concrétiser et de définir les bases pour étendre cet effort dans le futur à des dizaines d'autres espèces de microbes clé du microbiote intestinal humain, faisant ainsi participer la communauté scientifique au sens large. L’analyse du génome de ces modèles permettra de découvrir le potentiel des microbes intestinaux à produire des composés bioactifs, à communiquer entre eux et avec l'hôte, et à modifier leur environnement. De plus, l’étude servira d'exemple pour les initiatives futures concernant d'autres écosystèmes microbiens de la planète qui restent à explorer.
Athanasios Typas en quelques mots
Originaire de Grèce, Athanasios Typas effectue son doctorat en Allemagne en 2006 puis un séjour post-doctoral à San Francisco (États-Unis). En 2011, il installe son équipe de recherche à l’EMBL à Heidelberg (Allemagne) et depuis, il a astucieusement appliqué des méthodes de biologie à haut débit pour répondre aux questions les plus pertinentes dans le domaine des interactions hôte-microbiote. En plus d'être un scientifique très productif, le travail de Athanasios Typas est très collaboratif et a un grand impact sur la communauté microbiologique mondiale.

Prix Liliane Bettencourt pour les sciences du vivant
Le Prix Liliane Bettencourt pour les sciences du vivant récompense chaque année un chercheur de moins de 45 ans pour l’excellence de ses travaux et sa contribution remarquable à son domaine de recherche scientifique. Ce prix est attribué selon les années à un chercheur établi en France ou travaillant dans un autre pays d'Europe. Vingt-sept lauréats ont été récompensés depuis 1997. A partir de 2023, la dotation de ce prix récompense personnellement le lauréat à hauteur de 100 000 euros.
Tous les lauréats du prixAppel à candidatures
L’édition 2026 du prix récompensera un chercheur européen ou une chercheuse européenne travaillant dans un pays d’Europe, hors France. L'appel à nomination des candidats auprès de personnalités scientifiques sera ouvert entre le 9 janvier 2026 et le 9 mars 2026. Les candidats nominés pourront déposer leur candidature entre le mardi 10 mars 2026 et le mardi 5 mai 2026.








